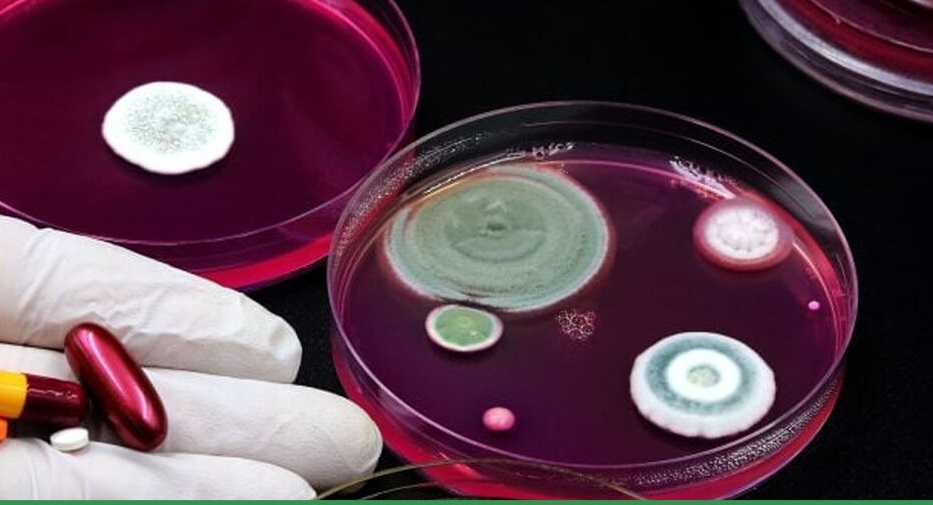

مقاومت دارویی به مرز هشدار رسید
شفاآنلاین »سلامت» یک متخصص بیماریهای عفونی هشدار داد که مقاومت آنتیبیوتیکی به مرحلهای خطرناک رسیده و بسیاری از درمانها اکنون بیاثر شدهاند. او تأکید کرد که مصرف خودسرانه آنتیبیوتیکها در جامعه ایرانی نقش مهمی در گسترش این بحران ایفا کرده است.
به گزارش شفاآنلاین فرشاد دیوسالار، متخصص بیماریهای عفونی و عضو هیئت علمی دانشگاه علوم پزشکی ایران، نسبت به بحران جدی مقاومت آنتیبیوتیکی که در حال گسترش است، هشدار داده و از وضعیت نگرانکننده درمان عفونتها سخن گفته است. به گفته وی، مقاومت به آنتیبیوتیکها به یکی از معضلات عمده بهداشت جهانی تبدیل شده است و دیگر بسیاری از داروها اثر درمانی ندارند.
مقاومت آنتیبیوتیکی؛ تهدیدی که جان میلیونها نفر را به خطر میاندازد
دیوسالار توضیح داد که در حال حاضر با یک دشمن در دنیای پزشکی روبهرو هستیم که سلاحهای ما علیه آن کارایی ندارد. «بسیاری از آنتیبیوتیکها بیاثر شدهاند و درمانهای معمولی دیگر نمیتوانند عفونتها را کنترل کنند.» طبق آمار جهانی، در سال ۲۰۱۹ مقاومت آنتیبیوتیکی مستقیماً باعث مرگ ۱.۲۷ میلیون نفر و بهطور غیرمستقیم بیش از ۵ میلیون مرگ در سراسر جهان شده است.
مصرف خودسرانه؛ عامل اصلی گسترش سویههای مقاوم
یکی از مهمترین علل گسترش مقاومت دارویی در کشورها، بهویژه در ایران، مصرف خودسرانه آنتیبیوتیکها است. دیوسالار با اشاره به آمارها اظهار کرد که در ایران، بیش از ۸۶ درصد مردم بدون تجویز پزشک، آنتیبیوتیک مصرف میکنند. این رفتار، بهویژه در درمان بیماریهای ویروسی مانند سرماخوردگی، سبب افزایش سویههای مقاوم میشود.
وضعیت نگرانکننده در بیمارستانها
متخصص بیماریهای عفونی به وضعیت بیمارستانها نیز اشاره کرد و گفت: «در برخی از بخشهای مراقبتهای ویژه (ICU) با میکروبهایی مواجه هستیم که به تمام آنتیبیوتیکهای موجود مقاوم شدهاند.» بهگفته وی، این وضعیت به این معناست که بیماران در برابر عفونتها هیچ سلاح درمانی ندارند و احتمال مرگ قطعی آنان افزایش مییابد.
راهکارهای کنترل مقاومت آنتیبیوتیکی
برای مقابله با این بحران، دیوسالار چند راهکار اساسی را مطرح کرد:
-
پرهیز از مصرف خودسرانه آنتیبیوتیکها: مصرف آنتیبیوتیکها باید تنها بر اساس تجویز پزشک و در شرایط ضروری انجام شود، بهویژه در بیماریهای ویروسی که آنتیبیوتیکها هیچ تأثیری ندارند.
-
تجویز مسئولانه آنتیبیوتیکها توسط پزشکان: پزشکان باید آنتیبیوتیکها را با دوز مناسب تجویز کرده و مصرف آنها را بهطور مداوم بازبینی کنند.
-
رعایت دقیق بهداشت در بیمارستانها: پرسنل بیمارستانها باید به دقت به بهداشت دستها و اصول بهداشت فردی توجه داشته باشند تا از انتشار میکروبهای مقاوم جلوگیری شود.
-
اجرای برنامههای مدیریت مصرف آنتیبیوتیک: در مراکز درمانی باید برنامههای مدیریت مصرف آنتیبیوتیک (Stewardship) بهطور جدی اجرا شود تا از مصرف نابجا و بیرویه جلوگیری شود.
-
آموزش عمومی برای کاهش مصرف نابجا: اطلاعرسانی و آموزش به مردم درباره خطرات مصرف بیرویه آنتیبیوتیکها، بهویژه در شرایطی که به آنها نیازی نیست، ضروری است.
آیندهای نگرانکننده: اگر امروز اقدامی نکنیم...
دیوسالار با اشاره به شعار سال ۲۰۲۳ سازمان بهداشت جهانی گفت: «اگر امروز اقدام نکنیم، در آینده نزدیک ممکن است برای درمان عفونتهای ساده، حتی دارویی در دسترس نداشته باشیم.» او هشدار داد که ممکن است روزی یکی از عزیزان ما به دلیل ابتلا به میکروبهایی که به تمام آنتیبیوتیکها مقاوم شدهاند، جان خود را از دست بدهد.
امید به آینده با آگاهی و مدیریت مصرف دارو
با این حال، دیوسالار ابراز امیدواری کرد که با افزایش آگاهی عمومی و مدیریت صحیح مصرف آنتیبیوتیکها، بتوان آیندهای ایمنتر و پایدارتر برای سلامت جامعه رقم زد. او تأکید کرد که این بحران تنها با همکاری مشترک مردم، پزشکان و نهادهای بهداشتی قابل کنترل است.
مقاومت آنتیبیوتیکی اکنون به یکی از تهدیدات جدی سلامت عمومی تبدیل شده است و نیاز به اقدام فوری برای کنترل مصرف دارو و پیشگیری از این بحران بیشتر از همیشه احساس میشود. تنها با همکاری و آگاهی میتوان از بروز عوارض و مرگومیرهای ناشی از این پدیده جلوگیری کرد.

